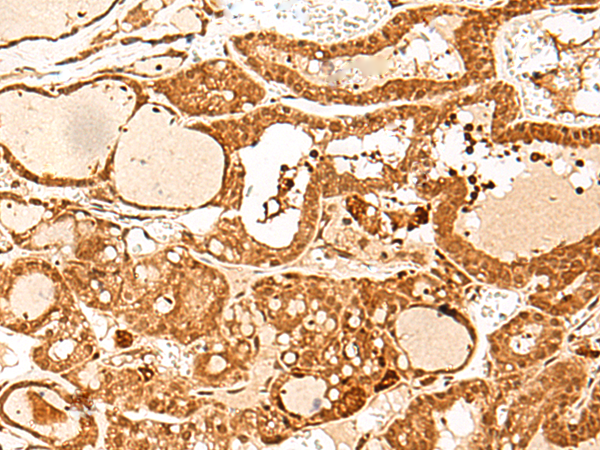

中文名稱: 兔抗GTF3C3多克隆抗體
英文名稱: Anti-GTF3C3 rabbit polyclonal antibody
別 名: general transcription factor IIIC subunit 3; TFIIIC102; TFIIICgamma; TFiiiC2-102
相關類別: 一抗
儲 存: 冷凍(-20℃)
宿 主: Rabbit
抗 原: GTF3C3
反應種屬: Human
標 記 物: Unconjugate
克隆類型: rabbit polyclonal
Background:
The protein encoded by this gene is part of the TFIIIC2 complex, which binds to the promoters of small nuclear and cytoplasmic RNA genes in order to recruit RNA polymerase III. The TFIIIC2 complex is composed of six subunits. Two transcript variants encoding different isoforms have been found for this gene.
Applications:
ELISA, IHC
Name of antibody:
GTF3C3
Immunogen:
Synthetic peptide of human GTF3C3
Full name:
general transcription factor IIIC subunit 3
Synonyms:
TFIIIC102; TFIIICgamma; TFiiiC2-102
SwissProt:
Q9Y5Q9
ELISA Recommended dilution:
5000-10000
IHC positive control:
Human thyroid cancer and Human ovarian cancer
IHC Recommend dilution:
40-200
技術規(guī)格

購物車
購物車 幫助
幫助
 021-54845833/15800441009
021-54845833/15800441009
